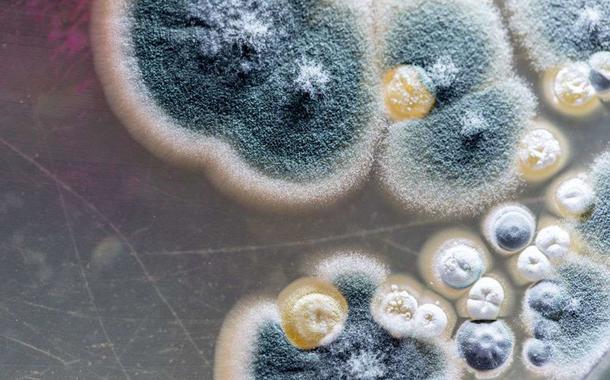

Flávio Dino sorteará prêmios de até R$ 10 mil para quem tomar a segunda dose da vacina
Campanha do governo do Maranhão tem como objetivo estimular população para que tome segunda dose da vacina, essencial na imunização contra a Covid-19

Campanha do governo do Maranhão tem como objetivo estimular população para que tome segunda dose da vacina, essencial na imunização contra a Covid-19

Anúncio foi feito pelo governador Flávio Dino e faz referência a Alcântara, onde todos os grupos da população passaram a ter acesso à primeira dose da vacina. Apenas duas cidades do País foram...

O desembargador afirmou ainda que é um entusiasta das Forças Armadas

Em março, o governo do Ceará assinou contrato para a compra direta da vacina russa Sputnik V. A previsão era adquirir 5,87 milhões de doses. Após a aprovação da Anvisa, o Ceará deve receber 183 mil...

O governador do Ceará alertou que o discurso e a postura de Jair Bolsonaro (sem partido) estimulam motins de policiais, como o deflagrado no ano passado em seu estado e reações violentas como nos...

Tenente-coronel Marcos Vanderlei foi exonerado do cargo de subcomandante do Comando de Policiamento da Capital

"Em Timon, a ‘MOTOCADA’ do bem está acontecendo. A pessoa pega a moto para ir se vacinar, não para passeios liderados por um irresponsável", escreveu o governador do Maranhão, Flávio Dino, nas...

Os próximos destinos do ex-presidente devem ser Bahia, Pernambuco, Ceará, Piauí e Maranhão. No Rio de Janeiro o petista teve uma intensa agenda de encontros e diálogos

Um grupo de manifestantes realizou nas ruas do centro de Salvador a “Marcha do Silêncio contra o Genocídio”, pedindo a saída de Jair Bolsonaro da presidência, destacando o alto número de mortes por...

“Não tem cabimento que os homens que me agrediram ainda achem que têm o direito de julgar a maneira como eu me visto, a maneira como eu uso meus cabelos. Isso é só mais uma camada dessas agressões...

“Sendo uma missão confiada a mim por Lula, será uma honra”, disse o governador do Piauí, Wellington Dias, ao comentar a possibilidade de coordenar a campanha do ex-presidente na eleição de 2022

O novo “Arraial de Vacinação“ vai durar 41 horas, da sexta-feira até domingo. Governo vai entregar mingau de milho de brinde

Agredida pela PM num ato contra Bolsonaro, a vereadora do Recife Liana Cirne Lins (PT) informou que recorreu à OAB devido ao machismo do advogado Rafael Nunes, que defende os PMs. “O advogado dos...

O governador do Maranhão pelo PCdoB alertou que não se deve subestimar o risco de o governo Jair Bolsonaro dar um golpe no País. De acordo com Flávio Dino, a Frente Ampla é necessária para derrotar...

Daniel Campelo, de 51 anos, atingido por uma bala de borracha no olho durante a manifestação do dia 29 de maio contra Jair Bolsonaro desabafa: “Qual a ameaça de cidadãos procurando seus direitos e...
De acordo com o infectologista Tiago Ferraz, a infecção aconteceu trinta dias após os primeiros sintomas da Covid-19 em uma paciente de 59 anos. Este ano o Brasil notificou 29 casos da mucormicose,...

"Não falha: Trump, Moro, Macri, agora esse Caboclo. Só se juntar com a família miliciana ou seus asseclas que vem a decadência. Lição importante para os que acham que “emendas” resolvem tudo...",...

O ex-comandante Vanildo Maranhão teria dado a ordem para que os PMs atacassem os manifestantes durante manifestação contra Jair Bolsonaro no último dia 29 de maio

Os governadores do Consórcio Nordeste e Amazônia Legal se reuniram neste sábado (5) para tratar de detalhes sobre a distribuição da vacina russa Sputnik V, após a Anvisa liberar o uso emergencial...

Decisão foi tomada há pouco, de modo excepcional e temporário, que permite a importação da Sputnik V por estados do Nordeste. Governadores da região compraram um total de 37 milhões de doses do...

Sob intensa pressão política e da sociedade, Antônio de Pádua entregou o cargo ao governador Paulo Câmara (PSB), que aceitou e nomeou como interino o atual secretário executivo, Humberto Freire